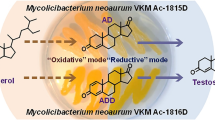

Abstract—
New methods for testosterone production from phytosterol were developed based on its cascade two-stage transformation by actinobacteria Mycolicibacterium neoaurum VKM Ac-1815D and Nocardioides simplex VKM Ac-2033D. Efficient oxidation of the phytosterol side chain by M. neoaurum resulted in formation of the main and side products: androst-4-en-3,20-dione (AD) and androsta-1,4-dien-3,20-dione (ADD), respectively, which were subsequently converted to testosterone by N. simplex. The latter reaction was reversible and catalyzed by the membrane-associated 17β-hydroxysteroid dehydrogenase (17β-HSD) capable of both oxidation and reduction of androstendione at C17. Addition of glucose and limited aeration were found to be the key factors providing for a shift of the 17β-HSD activity towards reduction in whole N. simplex cells. Testosterone production from phytosterol was realized using two approaches: (i) based on M. neoaurum cells inactivation after phytosterol conversion and application of the resting N. simplex biomass for androstenedione reduction and (ii) based on sequential application of the two living cultures. Under optimized conditions, the total yield of testosterone from phytosterol (10 g/L) reached 53 mol %. The results exceeded those reported so far for cascade phytosterol bioconversion to testosterone and may be used as a basis for development of new biotechnologies for production of the valuable steroid compounds, intermediates in the synthesis of modern medical preparations.
Similar content being viewed by others
Avoid common mistakes on your manuscript.
Testosterone (androst-4-en-17β-ol-3-one) is an androgen steroid hormone, an agonist of androgen receptors. It is widely used in medicine and veterinary and is also used as an important precursor for synthesis of certain pharmaceuticals. Direct chemical synthesis of testosterone is difficult due to the complexity and asymmetric tetracyclic structure of the steroid nucleus. Testosterone is presently produced from androst-4-en-3,20-dione (AD) using chemical or enzymatic methods (Perez et al., 2006). Medical application of synthesized testosterone may cause adverse reactions (Sood et al., 2016).
Biotechnological production of testosterone from the cheap and easily available phytosterol is promising due to its environmental friendliness and economical attractiveness. Phytosterol is a mixture of plant-produced sterols, which could be obtained from the wastes of oil and paper industries (Donova et al., 2005a). Direct biotechnological transformation of phytosterol to testosterone has been investigated using the cultures of Mycobacterium sp. (Lo et al., 2002), Mycobacterium sp. VKM Ac-1815D, and Mycobacterium sp. VKM Ac-1816D (Egorova et al., 2009). In these works, however, relatively low initial phytosterol concentrations were used (0.1‒5 g/L), and the obtained testosterone molar yields were 31‒55%.
According to the results of full-genome sequencing and phylogenetic analysis (Bragin et al., 2013; Shtratnikova et al., 2014), the isolates VKM Ac-1815D and VKM Ac-1816D were identified as M. neoaurum strain. Moreover, in 2018 a phylogenetically related group of mycobacteria, comprising rapidly growing saprotrophic strains of this species, was reclassified as the genus Mycolicibacterium (Gupta et al., 2018). The modern name of strains VKM Ac-1815D and VKM Ac-1816D is therefore Mycolicibacterium neoaurum.
M. neoaurum strain VKM Ac-1815D may form AD from phytosterol as the main product, since activity of 3-ketosteroid-9α-hydroxylase, the key enzyme for the degradation of the steroid nucleus, is blocked in this strain and the activity of 3-oxosteroid-Δ1-dehydrogenase is suppressed, while the enzymes oxidizing the aliphatic side chain of phytosterol at C17 function efficiently (Bragin et al., 2013). Further reduction of AD 17-keto group with production of testosterone may be carried out using Nocardioides simplex strain VKM Ac-2033D (Sukhodolskaya et al., 2017).
Low availability of steroids to microbial cells resulting from extremely poor solubility in water is one of the factors hindering efficient steroid biotransformation (Goetschel and Bar, 1992). This problem may be partially solved by applying water-mixable organic solvents and detergents (Sharma et al., 2012; Shao et al., 2016; Fernandez-Cabezon et al., 2017). Another approach involves application of cyclic oligosaccharides, cyclodextrins and especially their chemically modified derivatives, e.g., methylated β-cyclodextrin (MCD), which provide for higher solubility of lipophilic compounds even at high concentrations of the latter. Increased bioconversion efficiency in the presence of MCD was shown for sterol transformation by various actinobacteria (Donova et al., 2007; Shen et al., 2011), as well as for AD reduction to testosterone by Saccharomyces cerevisiae yeasts (Singer et al., 1991) and the mutant strain Mycobacterium sp. Et1 (Egorova et al., 2009), for reduction of androsta-1,4-dien-3,20-dione (ADD) to 1(2)-dehydrotestosterone by two sequentially used cultures: Arthrobacter simplex CPCC 140451 and Pichia pastoris GS115 (Tang et al., 2019a), and for other processes of steroid biotransformation.
Several cascade microbial processes of steroid biotransformation have been described previously. Thus, cholesterol biotransformation to ADD was carried out by sequential application of A. simplex strain U-S-A-18 (=Rhodococcus equi USA-18; Yeh et al., 2014) and Mycobacterium sp. strain NRRLB-3683 (Lee et al., 1993). We have developed an efficient method for production of 11α-hydroxy-AD from phytosterol involving its oxidation to AD by M. neoaurum VKM Ac-1815D and its subsequent selective 11α-hydroxylation by the fungal strain Aspergillus ochraceus VKM F-830 carried out in one bioreactor (Dovbnya et al., 2017). A recently described two-stage method for production of 1(2)-dehydrotestosterone from AD involved AD 1(2)-dehydration by A. simplex CPCC 140451, inactivation of bacterial cells, and subsequent 17β-reduction of produced ADD to 1(2)-dehydrotestosterone by a recombinant yeast strain P. pastoris GS115 (Tang et al., 2019a). Another method for production of 1(2)-dehydrotestosterone developed by the same authors involved two-stage phytosterol conversion by the mutant strains M. neoaurum TCCC 11028 and P. pastoris GS115, with overexpression of the genes encoding 3-oxosteroid-Δ1-dehydrogenase and 17β-hydroxysteroid dehydrogenase (17β-HSD), respectively (Tang et al., 2019b).
In the present work, the possibility of cascade microbial production of testosterone from phytosterol using the strains M. neoaurum VKM Ac-1815D and N. simplex VKM Ac-2033D was investigated. Phyto-sterol transformation by these strains was carried out either sequentially, with inactivation of M. neoaurum cells after completion of the first stage, followed by introduction of the resting N. simplex cells, or without M. neoaurum inactivation and with introduction of N. simplex directly into the growth medium. Approaches promoting efficient testosterone production at high phytosterol loads are proposed.
MATERIALS AND METHODS
Reagents. The following reagents were used: phytosterol with 95.47% total sterols content (Jiangsu Fruit Biological Products Co., Ltd., China); androstenedione (AD), androstadiendione (ADD), testosterone, and 1(2)-dehydrotestosterone (Steraloids, United States); NAD, NAD(H), and α,α-dipyridil (Merk, Germany); yeast extract (Difco, United States); soy peptone (Hi Media, India); and MCD (Wacker Chemie, Germany). Other reagents were produced by Russian domestic companies and qualified as chemically pure or pure for analysis.
Microbial strains. The strains M. neoaurum VKM Ac-1815D and N. simplex VKM Ac-2033D were obtained from the All-Russian Collection of Microorganisms, Skryabin Institute of Biochemistry and Physiology of Microorganisms, Russian Academy of Sciences (VKM).
Cultivation. M. neoaurum VKM Ac-1815D and N. simplex VKM Ac-2033D were grown for 48 h at 30°C. M. neoaurum was grown in the medium containing the following (g/L): K2HPO4·3H2O, 0.5; KH2-PO4, 0.5; (NH4)2HPO4, 1.5; glycerol, 10.0; and yeast extract, 10.0. N. simplex was grown in the medium containing the following (g/L): K2HPO4·3H2O, 4.0; KH2PO4, 2.0; yeast extract, 6.0; soy peptone, 6.0; and glucose, 15.0. Both media were prepared using distilled water and mineral salts (g/L): MgSO4·7H2O, 0.2; FeSO4·7H2O, 0.005; ZnSO4·7H2O, 0.002; pH was adjusted to 7.0–7.2 prior to sterilization. The strains were grown aerobically on an orbital shaker incubator (200 rpm) at 30°C.
In vitro determination of N. simplex 17β-HSD intracellular localization and activity. N. simplex cells were frozen at 70°С, homogenized in a French press (10.3 MPa), and resuspended in 40 mL of 50 mM Tris-HCl supplemented with 1 mM EDTA, pH 8 (buffer A). The cell debris was separated by centrifugation for 2 h at 30 000 g, 4°С. The membrane fractions were obtained by centrifugation of the supernatant for 3 h at 100 000 g, 4°С. The membrane fractions were then resuspended in buffer A (40 mL) and centrifuged again (Fig. 1).
Activity of the fractions towards AD and ADD was determined in the presence of NAD(H); activity against testosterone was measured in the presence of NAD. The reaction mixture contained the following: 100 mM Tris-HCl buffer (pH 7.0); 100 mM NaCl; 1.4 mM NADН or NAD (as stated in the text), 120 mM of the substrate; 500 µL of the active cell fractions; and 2 mL distilled water. The mixture was incubated for 15 h at 30°С under microaerophilic (without agitation) and aerophilic conditions (on an orbital shaker at 120 rpm). Steroids were extracted with ethyl acetate; the extract was then evaporated, and resuspended in ethanol for TLC analysis.
AD and ADD bioconversion by N. simplex. N. simplex culture was grown as described previously (Sukhodolskaya et al., 2017); the cells were collected by centrifugation (4000 rpm, 30 min, 4°С), resuspended in 0.02 M Na phosphate buffer (pH 7.0) to 8 g/L (dry biomass), and then supplemented with glucose (20 g/L) and AD or ADD (2 g/L) dissolved in dimethyl sulfoxide (DMSO) (4% vol/vol). Incubation was carried out at 30°С under microaerophilic conditions, in 100-mL flasks with 50 mL of the final mixture (at the 1 : 1 ratio of the liquid and gas phases) at slow stirring (70 rpm).
Cascade bioconversion of phytosterol to testosterone. Phytosterol (10 g/L) transformation by M. neoaurum was carried out in the medium for Mycolicibacterium (Egorova et al., 2002), as described previously (Bragin et al., 2013), in the presence of MCD at the phytosterol‒MCD ratios from 1 : 0.8 to 1 : 1.6.
For approach 1, after phytosterol transformation to AD was completed (as determined by TLC), a 50-mL aliquot of the M. neoaurum culture was inactivated by heating for 20 min at 50°С, transferred into a 100-mL flask, and supplemented with glucose (20 g/L) and N. simplex cells (4‒36 g dry biomass/L, as stated in the text) harvested by centrifugation (4000 g, 30 min, 4°С). In some experiments, α,α-dipyridil (4 mg/L), methanol (0.5‒4%, vol/vol), dimethyl formamide (1‒4%, vol/vol), or DMSO (2‒8%, vol/vol) were added. The initial pH of the medium was 7‒8 (as stated in the text).
For approach 2, M. neoaurum cells were not inactivated, and the culture liquid with Mycolicibacterium cells (25 mL) was transferred into a 100-mL flask containing 25 mL of the N. simplex culture (8 g/L, dry biomass) in the stationary growth phase (48 h), and supplemented with glucose (20 g/L) or glycerol (10 g/L), α,α-dipyridil (4 mg/L), DMSO (4%, vol/vol); pH of the mixture was adjusted to 8. The transformation was carried out at 30°С under microaerophilic conditions (in 100-mL flasks with 50 mL of the culture (1 : 1 ratio of the liquid and gas phases) at slow stirring (100 rpm).
Dry biomass determination. Prior to the second centrifugation, the cells N. simplex were washed off the medium with 0.02 M phosphate buffer, pH 7.0. For determination of N. simplex dry biomass, the cells were harvested by centrifugation for 30 min (4000 g, 4°C) and dried at 105°C to constant weight.
Steroid analysis was carried out using thin-layer chromatography (TLC) and high-performance liquid chromatography (HPLC), as described previously (Lobastova et al., 2021).
Reproducibility and statistical tests. The experiments were carried out in three independent replicates, which were used to calculate the standard deviations, which are shown as error bars on the figures and in Table 1.
RESULTS AND DISCUSSION
In vitro study of 17β-hydroxysteroid dehydrogenase (17β-HSD) activity of the N. simplex strain. Activity of N. simplex cell fractions obtained as described above (Fig. 1) towards C19-steroids under aerophilic and microaerophilic conditions was tested. The activity of 17β-HSD was revealed only in the cell debris fraction. Under microaerophilic conditions in the presence of NAD(H), AD and ADD were converted to testosterone and 1(2)-dehydrotestosterone, respectively. ADD formation from AD was also observed, indicating 3‑oxosteroid-Δ1-dehydrogenase activity. The reverse reaction of hydrogenation of the С1‒С2 double bond, i.e., conversion of ADD to AD, was also observed (Table 1). The products of testosterone conversion under microaerophilic conditions were 1(2)-dehydrotestosterone, AD, and ADD (Table 1). Thus, under microaerophilic conditions 17β-reduction and 1(2)-hydration were carried out in parallel with 1(2)-dehydrogenation.
The rates of enzymatic NAD(H)-dependent reduction of AD and ADD 17-keto groups due to 17β-HSD activity were almost the same, and the total yields for 17β-reduced derivatives (testosterone and 1(2)-dehydrotestosterone) were 33 and 34% from AD and ADD, respectively (Table 1). Thus, in vivo experiments confirmed that efficient reduction of the 17‑keto group of 3,17-diketoandrostanes by N. simplex cells was possible only under reductive conditions.
Most of 17β-HSDs are able to catalyze redox reactions; however, activity of bacterial enzymes is usually shifted to oxidation of the C17 hydroxyl group, while fungal 17β-HSDs preferentially catalyze reduction of the C17 carbonyl group (Donova et al., 2005b; Fernandez-Cabezon et al., 2017).
Reversible oxidation of the C1‒C2 double bond in the steroid nucleus has been reported previously (Hung et al., 1994; Egorova et al., 2002). Microbial reduction of ADD to testosterone involving reduction of both the C1‒C2 double bond and the C17-keto group is known to be sometimes more efficient than reduction of only the C17-keto group of AD (Hung et al., 1994; Egorova et al., 2009). This has been shown for Nocardia strains (Sharma et al., 2012) and confirmed for N. simplex (Table 1). A high NAD(H) level is required for efficient reduction of the 17-keto group (Fogal et al., 2010).
Thus, efficient reduction of the C17-carbonyl group of 3,17-diketoandrostanes by N. simplex VKM Ac-2033D requires reductive conditions: decreased concentration of dissolved oxygen and the pool of reductive cofactors (NAD(H)).
Further experiments were carried out in vivo in the presence of glucose (20 g/L) under microaerophilic conditions, which were established by using high biomass of resting N. simplex cells, weak agitation, and decreased volume of the gas phase.
In vivo biotransformation of AD and ADD by the N. simplex strain. Transformation of exogenous chemically pure AD and ADD by N. simplex cells was studied in model experiments (Figs. 2a and 3). This study was required to confirm the feasibility of the cascade scheme in which N. simplex is added to the culture liquid containing AD(+ADD) and obtained at phytosterol transformation by M. neoaurum.
Scheme of the experiments, in which chemically pure exogenous AD and ADD are transformed by resting N. simplex VKM Ac-2033D cells (a); cascade biotransformation of 10 g/L phytosterol to testosterone using inactivated M. neoaurum VKM Ac-1815D culture and resting N. simplex VKM Ac-2033D cells (b); or biotransformation by non-inactivated M. neoaurum VKM Ac-1815D culture and N. simplex VKM Ac-2033D cells (b1). Designations: Ph, phytosterol; T, testosterone; dT, 1(2)-dehydrotestosterone; VGP and VLP, volumes of the gas and liquid phases, respectively; V1 and V2, volumes of M. neoaurum and N. simplex cultures, respectively.
Under these conditions, ADD was almost completely transformed by N. simplex cells to 1(2)-dehydrotestosterone after 72 h (Fig. 3a). AD biotransformation to testosterone was active only during the first hours of incubation, while 40.8 ± 2.7 mol % of testosterone was accumulated after 8 h of conversion (Fig. 3b, curve 4); then testosterone oxidation back to AD occurred (Fig. 3b, curves 3 and 4). Activity of 17β-HSD in microbial cells is known to depend on the ratio between NAD(H) and NAD (Kristan et al., 2003). Exhaustion of the NAD(H) pool in the course of AD transformation is known to be responsible for the shift of 17β-HSD activity to oxidation.
Glucose may have a positive effect on recycling of reduced NAD. Thus, undesirable oxidation of testosterone to AD decreased after addition of glucose in the case of strains Rhodococcus ruber Chol-4 and Lactobacillus bulgaricus (Guevara et al., 2019).
Preferential oxidation of ADD (rather than AD) as the substrate for bacterial 17β-HSDs has been described previously (Singer et al., 1991; Egorova et al., 2009; Shao et al., 2016; Fernandez-Cabezon et al., 2017; Guevara et al., 2019). In some cases, no testosterone was produced from AD (Hung et al., 1994). The possible causes include higher AD toxicity for microorganisms and the differences in the physicochemical characteristics of AD and ADD (Fernandes et al., 2003; Egorova et al., 2009).
Cascade phytosterol transformation to testosterone using the inactivated M. neoaurum culture and subsequent introduction of resting N. simplex cells. The possibility of cascade phytosterol transformation to testosterone was studied for sequential application of M. neoaurum and N. simplex cultures, which converted phytosterol to AD(+ADD) and then to testosterone (Fig. 4), correspondingly.
Biotransformation of phytosterol (10 g/L) carried out by M. neoaurum (Fig. 4) resulted in production of 4.4 g/L AD and 0.5 g/L ADD. After heating of the M. neoaurum culture, precipitated resting N. simplex cells were resuspended in the culture liquid containing AD and ADD. The effects of MCD content, introduced N. simplex biomass, pH, type and concentration of organic solvents, and the inhibitor of 9α-hydroxylase activity were assessed in order to optimize bioconversion conditions.
Effect of MCD concentration on phytosterol cascade biotransformation. The total yield of AD and ADD (the first stage of the cascade process) increased with increasing MCD concentrations (Fig. 5, curve 1). However, the maximum testosterone yield at the second stage of the cascade process did not change significantly in the studied range of the phytosterol‒MCD molar ratios (from 1 : 0.8 to 1 : 1.4) (Fig. 5, curve 2). At the optimal MCD concentration, testosterone yield from phytosterol (10 g/L) in the variant with M. neoaurum inactivation was 35.3‒36.7 mol % (2.6–2.7 g/L).
Effect of MCD concentration on the total yield of AD and ADD at the stage of phytosterol (10 g/L) biotransformation by M. neoaurum VKM Ac-1815D (1), on testo-sterone yield (2), and residual AD concentration at the second stage of cascade bioconversion carried out by N. simplex VKM Ac-2033D according to the Fig. 2b (3).
As was noted above, cyclodextrins may affect not only steroids, but actinobacterial cells as well (Donova et al., 2007; Shen et al., 2011). Negative effect of MCD on Mycolicibacterium cells has not been reported, while the loss of both membrane and intracellular proteins by N. simplex in the medium with hydroxypropyl-β-cyclodextrin was over 40%, compared to the control without cyclodextrins (Shen et al., 2011). Decreased efficiency of AD transformation at cyclodextrin concentrations exceeding the optimal value has also been reported (Shao et al., 2016; Tang et al., 2019a).
Effect of the amount of the introduced N. simplex biomass. Increasing 3- to 9-fold the amount of resting N. simplex cells (from 4 to 36 g/L, dry biomass) had no significant effect on testosterone yield in cascade biotransformation (data not shown). However, for AD transformation by the recombinant strain P. pastoris GS115, a 5- to 6-fold increase in biomass (up to 200 g/L, wet biomass) almost doubled testosterone yield (Shao et al., 2016). In the case of cascade transformation of phytosterol by recombinant strains M. neoaurum TCCC 11028 and P. pastoris GS115, higher yeast biomass (175 g/L wet biomass) resulted in the highest yield of 1(2)-dehydrotestosterone (Tang et al., 2019b).
Effect of α,α-dipyridil. AD(D) biotransformation by N. simplex resulted in incomplete steroid material balance due to the presence of 9α-hydroxylase activity, which caused a cleavage of the B ring of the steroid nucleus of 1(2)-dehydrogenated derivatives (Shtratnikova et al., 2021). The bacterial 3-oxosteroid-9α-hydroxylase consists of subunits KshA (monooxyge-nase) and KshB (reductase) encoded by the genes kshA and kshB, respectively. Three orthologs of the kshA-gene were revealed in the genome of N. simplex (Shtratnikova et al., 2016); transcription of two of them was induced with phytosterol. Thus, the products of the kshA and kshB genes are probably responsible for the degradation of the steroid nucleus along the 9(10)-seco pathway in N. simplex (Shtratnikova et al., 2021).
In the present study, testosterone concentration did not increase after 24-h incubation of N. simplex in AD-containing culture liquid (Fig. 6, curve 2), while the levels of AD (Fig. 6, curve 3), ADD, and 1(2)-dehydrotestosterone decreased, probably due to cleavage of the steroid nucleus. Addition of α,α-dipyridil, a nonspecific inhibitor of 9α-hydroxylase, resulted in the increase of the period of testosterone accumulation to 72 h, with its final yield enhancement to 64.5–71.2 mol % (Fig. 6, curve 1), which indicated lower steroids degradation.
The effect of α,α-dipyridil on testosterone yield (1, 2) and residual AD concentrations (3, 4) during AD(+ADD)-rich culture liquid biotransformation by N. simplex VKM Ac-2033D: in the presence of 0.4 mg α,α-dipyridil (1, 4) and without α,α-dipyridil (2, 3). Biotransformation of 10 g/L phytosterol was carried out using the M. neoaurum VKM Ac-1815D strain according to the Fig. 2b with the yields of 4.4 g/L AD and 0.5 g/L ADD.
The effect of dimethyl sulfoxide (DMSO). Organic solvents and detergents are known to provide for the distribution of hydrophobic substrates (including steroids) in aquatic media, which results in higher bioconversion rates. Thus, resting cells of A. simplex (=N. simplex) strain TCCC 11037 treated with 8% ethanol (vol/vol) exhibited high 1(2)-dehydrogenase activity (Luo et al., 2014). On the other hand, organic solvents may cause damage of the cell membranes.
DMSO is a bipolar aprotonic organic solvent with relatively low toxicity, which may affect the permeability of cell membranes, thus facilitating substrate transfer into the cell, while not affecting its viability. In our experiments, methanol (0.5–4.0%, vol/vol) and dimethylformamide (1.0–4.0%, vol/vol) had low effect on testosterone production during the second stage of cascade biotransformation. Addition of 4% (vol/vol) DMSO resulted in testosterone yield increased by 11‒13 mol % (Fig. 7a).
The effect of pH and DMSO on testosterone accumulation during phytosterol transformation by resting N. simplex VKM Ac-2033D cells of AD(+ADD)-rich inactivated culture liquid of M. neoaurum VKM Ac-1815D. Biotransformation of 10 g/L phytosterol was carried out by the M. neoaurum strain (Fig. 2b) with the yields of 4.4 g/L AD and 0.5 g/L ADD. Initial pH of the AD(+ADD)-containing culture liquid of M. neoaurum was adjusted to 7.0 (a) or 8.0 (b). Curve designations: supplementation with 4% (vol/vol) DMSO (1) and without DMSO (2).
Effect of pH. The pH value was previously shown to affect AD biotransformation to testosterone by actinobacteria (Liu and Lo, 1997; Egorova et al., 2009; Fernandez-Cabezon et al., 2017). In the present work, the effect of pH on efficiency of the second stage of cascade phytosterol conversion in the range of pH 7.0–8.0 was determined. Reduction of the AD(D) 17-carbonyl group was most active at pH 8.0, with the highest testosterone yield of 50.4 mol % achieved after 48‒72 h. The combination of DMSO (4%, vol/vol) and pH 8.0 resulted in increased rate of testosterone accumulation and its titer as high as 3.6‒3.7 g/L, corresponding to 75.5 mol % at the second stage of the cascade process (AD → testosterone) (Fig. 7b). In this case, testosterone yield from phytosterol was 51.8–53.2 mol %.
Cascade biotransformation of phytosterol to testosterone using non-inactivated M. neoaurum culture and N. simplex cells in the growth medium. To simplify the scheme for testosterone production from phytosterol, the stages of M. neoaurum inactivation and separation of N. simplex cells by centrifugation were excluded. N. simplex cells were added directly to the culture liquid of M. neoaurum after phytosterol conversion to AD(+ADD) (Fig. 2b1).
Bioconversion of phytosterol (10 g/L) by M. neoaurum was carried out at the phytosterol/MCD molar ratio of 1 : 1.6, resulting in 4.8 g/L AD. Thus, the molar ratio of phytosterol to MCD at the second stage of cascade biotransformation was 1 : 0.8 (due to twofold dilution after addition of N. simplex culture). Application of this scheme resulted in testosterone yield of 2.40–2.65 g/L from 10 g/L phytosterol.
In the control variant (without N. simplex cells), testosterone accumulation was not observed. Replacing glucose with glycerol at the second stage resulted in a completely different course of biotransformation, with no production of testosterone and AD as the major steroid product.
Inactivation of the culture used at the first stage of cascade biotransformation has been reported to have a positive effect on the yield of the target product. Thus, AD biotransformation to 1(2)-dehydrotestosterone was inefficient when growing cultures of A. simplex CPCC 140451 and P. pastoris GS115 were added to the same bioreactor, while inactivation of A. simplex CPCC 140451 after the first stage of cascade biotransformation resulted in increased yield of 1(2)-dehydrotestosterone (Tang et al., 2019a). In another case, exclusion of the stage of cell inactivation by sterilization of the culture liquid in the process of phytosterol biotransformation by M. neoaurum M3M-ksdDR2 resulted in a 13% loss of 1(2)-dehydrotestosterone compared to the control (Tang et al., 2019b).
For industrial testosterone production, using growing cultures of M. neoaurum and N. simplex is practically advantageous compared to using resting N. simplex cells harvested by centrifugation and sterilized M. neoaurum culture liquid, since it decreases the duration of cascade biotransformation, as well as expense of equipment, energy, and labor.
The present work dealt with investigation of cascade two-stage biotransformation of phytosterol to testosterone using two actinobacterial strains, M. neoaurum VKM Ac-1815D and N. simplex VKM Ac-2033D, which carried out selective oxidative degradation of the phytosterol side chain and 17β-reduction of the resulting androstendiones to testosterone, respectively.
In vitro experiments showed that reduction of the 17-keto group of androstendiones (AD and ADD) was most efficiently catalyzed by membrane-bound enzymes under microaerophilic conditions in the presence of NAD(H). Unlike ADD reduction to 1(2)-dehydrotestosterone, reduction of AD, its 1(2)-saturated analogue, to testosterone by N. simplex cells was reversible. Efficient production of testosterone from AD required an increased pool of reductive equivalents, which may be achieved by addition of glucose and establishment of microaerophilic conditions. Cascade bioconversion of phytosterol to testosterone proved possible with both resting N. simplex cells and a growing culture of this strain. The conditions were determined, under which testosterone yield of up to 53 mol % was achieved at a high phytosterol concentration (10 g/L).
These results may be used to develop a biotechnology for testosterone production from renewable plant materials by two-stage microbial transformation of phytosterol in a “one-pot” process.
REFERENCES
Bragin, E.Y., Shtratnikova, V.Y., Dovbnya, D.V., Schelkunov, M.I., Pekov, Y.A., Malakho, S.G., Egoro-va, O.V., Ivashina, T.V., Sokolov, S.L., Ashapkin, V.V., and Donova, M.V., Comparative analysis of genes encoding key steroid core oxidation enzymes in fast-growing Mycobacterium spp. strains, J. Steroid Biochem. Mol. Biol., 2013, vol. 138, pp. 41–53.
Donova, M.V., Dovbnya, D.V., Sukhodolskaya, G.V., Khomutov, S.M., Nikolayeva, V.M., Kwon, I., and Han K., Microbial conversion of sterol-containing soybean oil production waste, J. Chem. Technol. Biotechnol., 2005a, vol. 80, pp. 155–160.
Donova, M.V., Egorova, O.V., and Nikolayeva, V.M., Steroid 17β-reduction by microorganism—a review, Process Biochem., 2005b, vol. 40, pp. 2253–2262.
Donova, M.V., Nikolayeva, V.M., Dovbnya, D.V. Gulevskaya, S.A., and Suzina, N.E., Methyl-β-cyclodextrin alters growth, activity and cell envelope features of sterol-transforming mycobacteria, Microbiology (SGM), 2007, vol. 153, pp. 1981–1992.
Dovbnya, D., Khomutov, S., Kollerov, V., and Donova, M.V., Obtaining of 11α-hydroxyandrost-4-ene-3,17-dione from natural sterols, in Microbial Steroids. Methods in Molecular Biology, 2017, vol. 1645, pp. 259–269.
Egorova, O.V., Gulevskaya, S.A., Puntus, I.F., Filonov, A.E., and Donova, M.V., Production of androstenedione using mutants of Mycobacterium sp., J. Chem. Technol. Biotechnol., 2002, vol. 77, pp. 141–147.
Egorova, O.V., Nikolayeva, V.M., Sukhodolskaya, G.V., and Donova, M.V., Transformation of C19-steroids and testosterone production by sterol-transforming strains of Mycobacterium spp., J. Mol. Catal. B Enzym., 2009, vol. 57, pp. 198–203.
Fernandes, P., Cruz, A., Angelova, B., Pinheiroa, H.M., and Cabral, J.M.S., Microbial conversion of steroid compounds: recent developments, Enzyme Microb. Technol., 2003, vol. 32, pp. 688–705.
Fernandez-Cabezon, L., Galan, B., and Garcia, J.L., Engineering Mycobacterium smegmatis for testosterone production, Microb. Biotechnol., 2017, vol. 10, pp. 151–161.
Fogal, S., Motterle, R., Castellin, A., Arvotti, G., and Bergantino, E. Biocatalyzed synthesis of testosterone, Chem. Eng. Trans., 2010, vol. 20, pp. 61–66.
Goetschel, R. and Bar, R., Formation of mixed crystals in microbial conversion of sterols and steroids, Enzyme Microb. Technol., 1992, vol. 14, pp. 462–469.
Guevara, G., Olortegui Flores, Y., Fernández de las Heras, L., Perera, J., and Navarro Llorens, J.M., Metabolic engineering of Rhodococcus ruber Chol-4: a cell factory for testosterone production, PLoS One, 2019, vol. 14, e0220492.
Gupta, R.S., Lo, B., and Son, J., Phylogenomics and comparative genomic studies robustly support division of the genus Mycobacterium into an emended genus Mycobacterium and four novel genera, Front. Microbiol., 2018, vol. 9, art. 67.
Hung, B., Falero, A., Llanes, N., Pérez, C., and Ramirez, M.A., Testosterone as biotransformation product in steroid conversion by Mycobacterium sp., Biotechnol. Lett., 1994, vol. 16, pp. 497–500.
Kristan, K., Rizner, T.L., Stojan, J., Gerber, J.K., Kremmer, E., and Adamski, J., Significance of individual amino acid residues for coenzyme and substrate specificity of 17β-hydroxysteroid dehydrogenase from the fungus Cochliobolus lunatus, Chem. Biol. Interact., 2003, vols. 143‒144, pp. 493–501.
Lee, C.H., Chen, C., and Liu, W.H., Production of androsta-1,4-diene-3,17-dione from cholesterol using two-step microbial transformation, Appl. Microbiol. Biotechnol., 1993, vol. 38, pp. 447–452.
Liu, W.H. and Lo, C.K., Production of testosterone from cholesterol using a single-step microbial transformation of Mycobacterium sp., J. Ind. Microbiol. Biotechnol., 1997, vol. 19, pp. 269–272.
Lo, C.K., Pan, C.P., and Liu W.H., Production of testosterone from phytosterol using a single-step microbial transformation by a mutant of Mycobacterium sp., J. Ind. Microbiol. Biotechnol., 2002, vol. 28, pp. 280–283.
Lobastova, T., Fokina, V.,Tarlachkov, S.,Shutov, A., Bragin, E., Kazantsev, A., and Donova, M., Steroid metabolism in thermophilic actinobacteria Saccharopolyspora hirsuta subsp. Hirsuta VKM Ac-666T, Microorganisms, 2021 Dec, vol. 9, no. 12, p. 2554.
Luo, J., Ning, J., Wang, Y., Cheng, Y., Zheng, Y., Shen, Y., and Wang, M., The effect of ethanol on cell properties and steroid 1-en-dehydrogenation biotransformation of Arthrobacter simplex, Biotechnol. Appl. Biochem., 2014, vol. 61, pp. 555‒564.
Perez, C., Falero, A., LuuDuc, H., Balcinde, Y., and Hung, B.R., A very efficient bioconversion of soybean phytosterols mixtures to androstanes by mycobacteria, J. Ind. Microbiol., 2006, vol. 33, pp. 719‒723.
Shao, M., Zhang, X., Rao, Z., Xu, M., Yang, T., Li, H., Xu, Z., and Yang, S., Efficient testosterone production by engineered Pichia pastoris co-expressing human 17β-hydroxysteroid dehydrogenase type 3 and Saccharomyces cerevisiae glucose 6-phosphate dehydrogenase with NADPH regeneration, Green Chem., 2016, vol. 18, pp. 1774–1784.
Sharma, P., Slathia, P., Somal, P., and Mehta, P., Biotransformation of cholesterol to 1,4-androstadiene-3,17-dione (ADD) by Nocardia species, Ann. Microbiol., 2012, vol. 62, pp. 1651–1659.
Shen, Y., Wang, M., Zhang, L., Ma, Y., Ma, B., and Zheng, Y., Effects of hydroxypropyl-β-cyclodextrin on cell growth, activity, and integrity of steroid-transforming Arthrobacter simplex and Mycobacterium sp., Appl. Microbiol. Biotechnol., 2011, vol. 90, pp. 1995–2003.
Shtratnikova, V., Schelkunov, M., Fokina, V., Bragin, E.Y., Shutov, A.A., and Donova, M.V., Different genome-wide transcriptome responses of Nocardioides simplex VKM Ac-2033D to phytosterol and cortisone 21-acetate, BMC Biotechnol., 2021, vol. 21, art. 7.
Shtratnikova, V.Y., Bragin, E.Y., Dovbnya, D.V., Pekov, Y.A., Schelkunov, M.I., Strizhov, N.I., Ivashina, T.V., Ashapkin, V.V., and Donova, M.V., Complete genome sequence of sterol transforming Mycobacterium neoaurum strain VKM 1815D, Genome Announc., 2014, vol. 2, pp. e01177-13.
Shtratnikova, V.Y., Schelkunov, V.I., Fokina, V.V., Pekov, Y.A., Ivashina, T., and Donova, M.V., Genome-wide bioinformatics analysis of steroid metabolism-associated genes in Nocardioides simplex VKM Ac-2033D, Curr. Genet., 2016, vol. 62, pp. 643–656.
Singer, Y., Shity, H., and Bar, R., Microbial transformations in a cyclodextrin medium. Part 2. Reduction of androstenedione to testosterone by Saccharomyces cerevisiae, Ap-pl. Microbiol. Biotechnol., 1991, vol. 35, pp. 731–737.
Sood, U., Singh, Y., Shakarad, M., and Lal, R., Highlight on engineering Mycobacterium smegmatis for testosterone production, Microb. Biotechnol., 2017, vol. 10, pp. 73–75.
Sukhodolskaya, G., Fokina, V., Shutov, A., Nikolayeva, V., Savinova, T., Grishin, Y., Kazantsev, A., Lukashev, N., and Donova, M., Bioconversion of 6-(N-methyl-N-phenyl)aminomethylandrostane steroids by Nocardioides simplex, Steroids, 2017, vol. 118, pp. 9–16.
Tang, R., Shen, Y., Wang, M., Zhou, H., and Zhao, Y. Highly efficient synthesis of boldenone from androst-4-ene-3,17-dione by Arthrobacter simplex and Pichia pastoris ordered biotransformation, Bioproc. Biosyst. Eng., 2019a, vol. 42, pp. 933–940.
Tang, R., Shen, Y., Xia, M., Tu, L., Luo, J., Geng, Y., Gao, T., Zhou, H., Zhao, Y., and Wang, M., A highly efficient step-wise biotransformation strategy for direct conversion of phytosterol to boldenone, Bioresour. Technol., 2019b, vol. 283, pp. 242–250.
Yeh, C.-H., Kuo, Y.-S., Chang, C.-M., Liu, W.-H., Sheu, M.-L., and Meng, M., Deletion of the gene encoding the reductase component of 3-ketosteroid 9α-hydroxylase in Rhodococcus equi USA-18 disrupts sterol catabolism, leading to the accumulation of 3-oxo-23,24-bisnorchola-1,4-dien-22-oic acid and 1,4-androstadiene-3,17-dione, Microb. Cell Fact., 2014, vol. 13, art. 130.
ACKNOWLEDGMENTS
The authors are grateful to G.V. Sukhodolskaya for the idea for this study and for her invaluable aid in selection and development of the research methods, obtaining and discussing the results, and formulation of the conclusions.
Funding
The work was supported by the Russian Science Foundation, project no. 21-64-00024.
Author information
Authors and Affiliations
Corresponding author
Ethics declarations
Conflict of interests. The authors declare that they have no conflict of interest.
Statement on the welfare of animals. This article does not contain any studies involving animals or human participants performed by any of the authors.
Additional information
Translated by P. Sigalevich
Rights and permissions
About this article
Cite this article
Tekucheva, D.N., Fokina, V.V., Nikolaeva, V.M. et al. Cascade Biotransformation of Phytosterol to Testosterone by Mycolicibacterium neoaurum VKM Ас-1815D and Nocardioides simplex VKM Ас-2033D Strains. Microbiology 91, 303–312 (2022). https://doi.org/10.1134/S0026261722300099
Received:
Revised:
Accepted:
Published:
Issue Date:
DOI: https://doi.org/10.1134/S0026261722300099